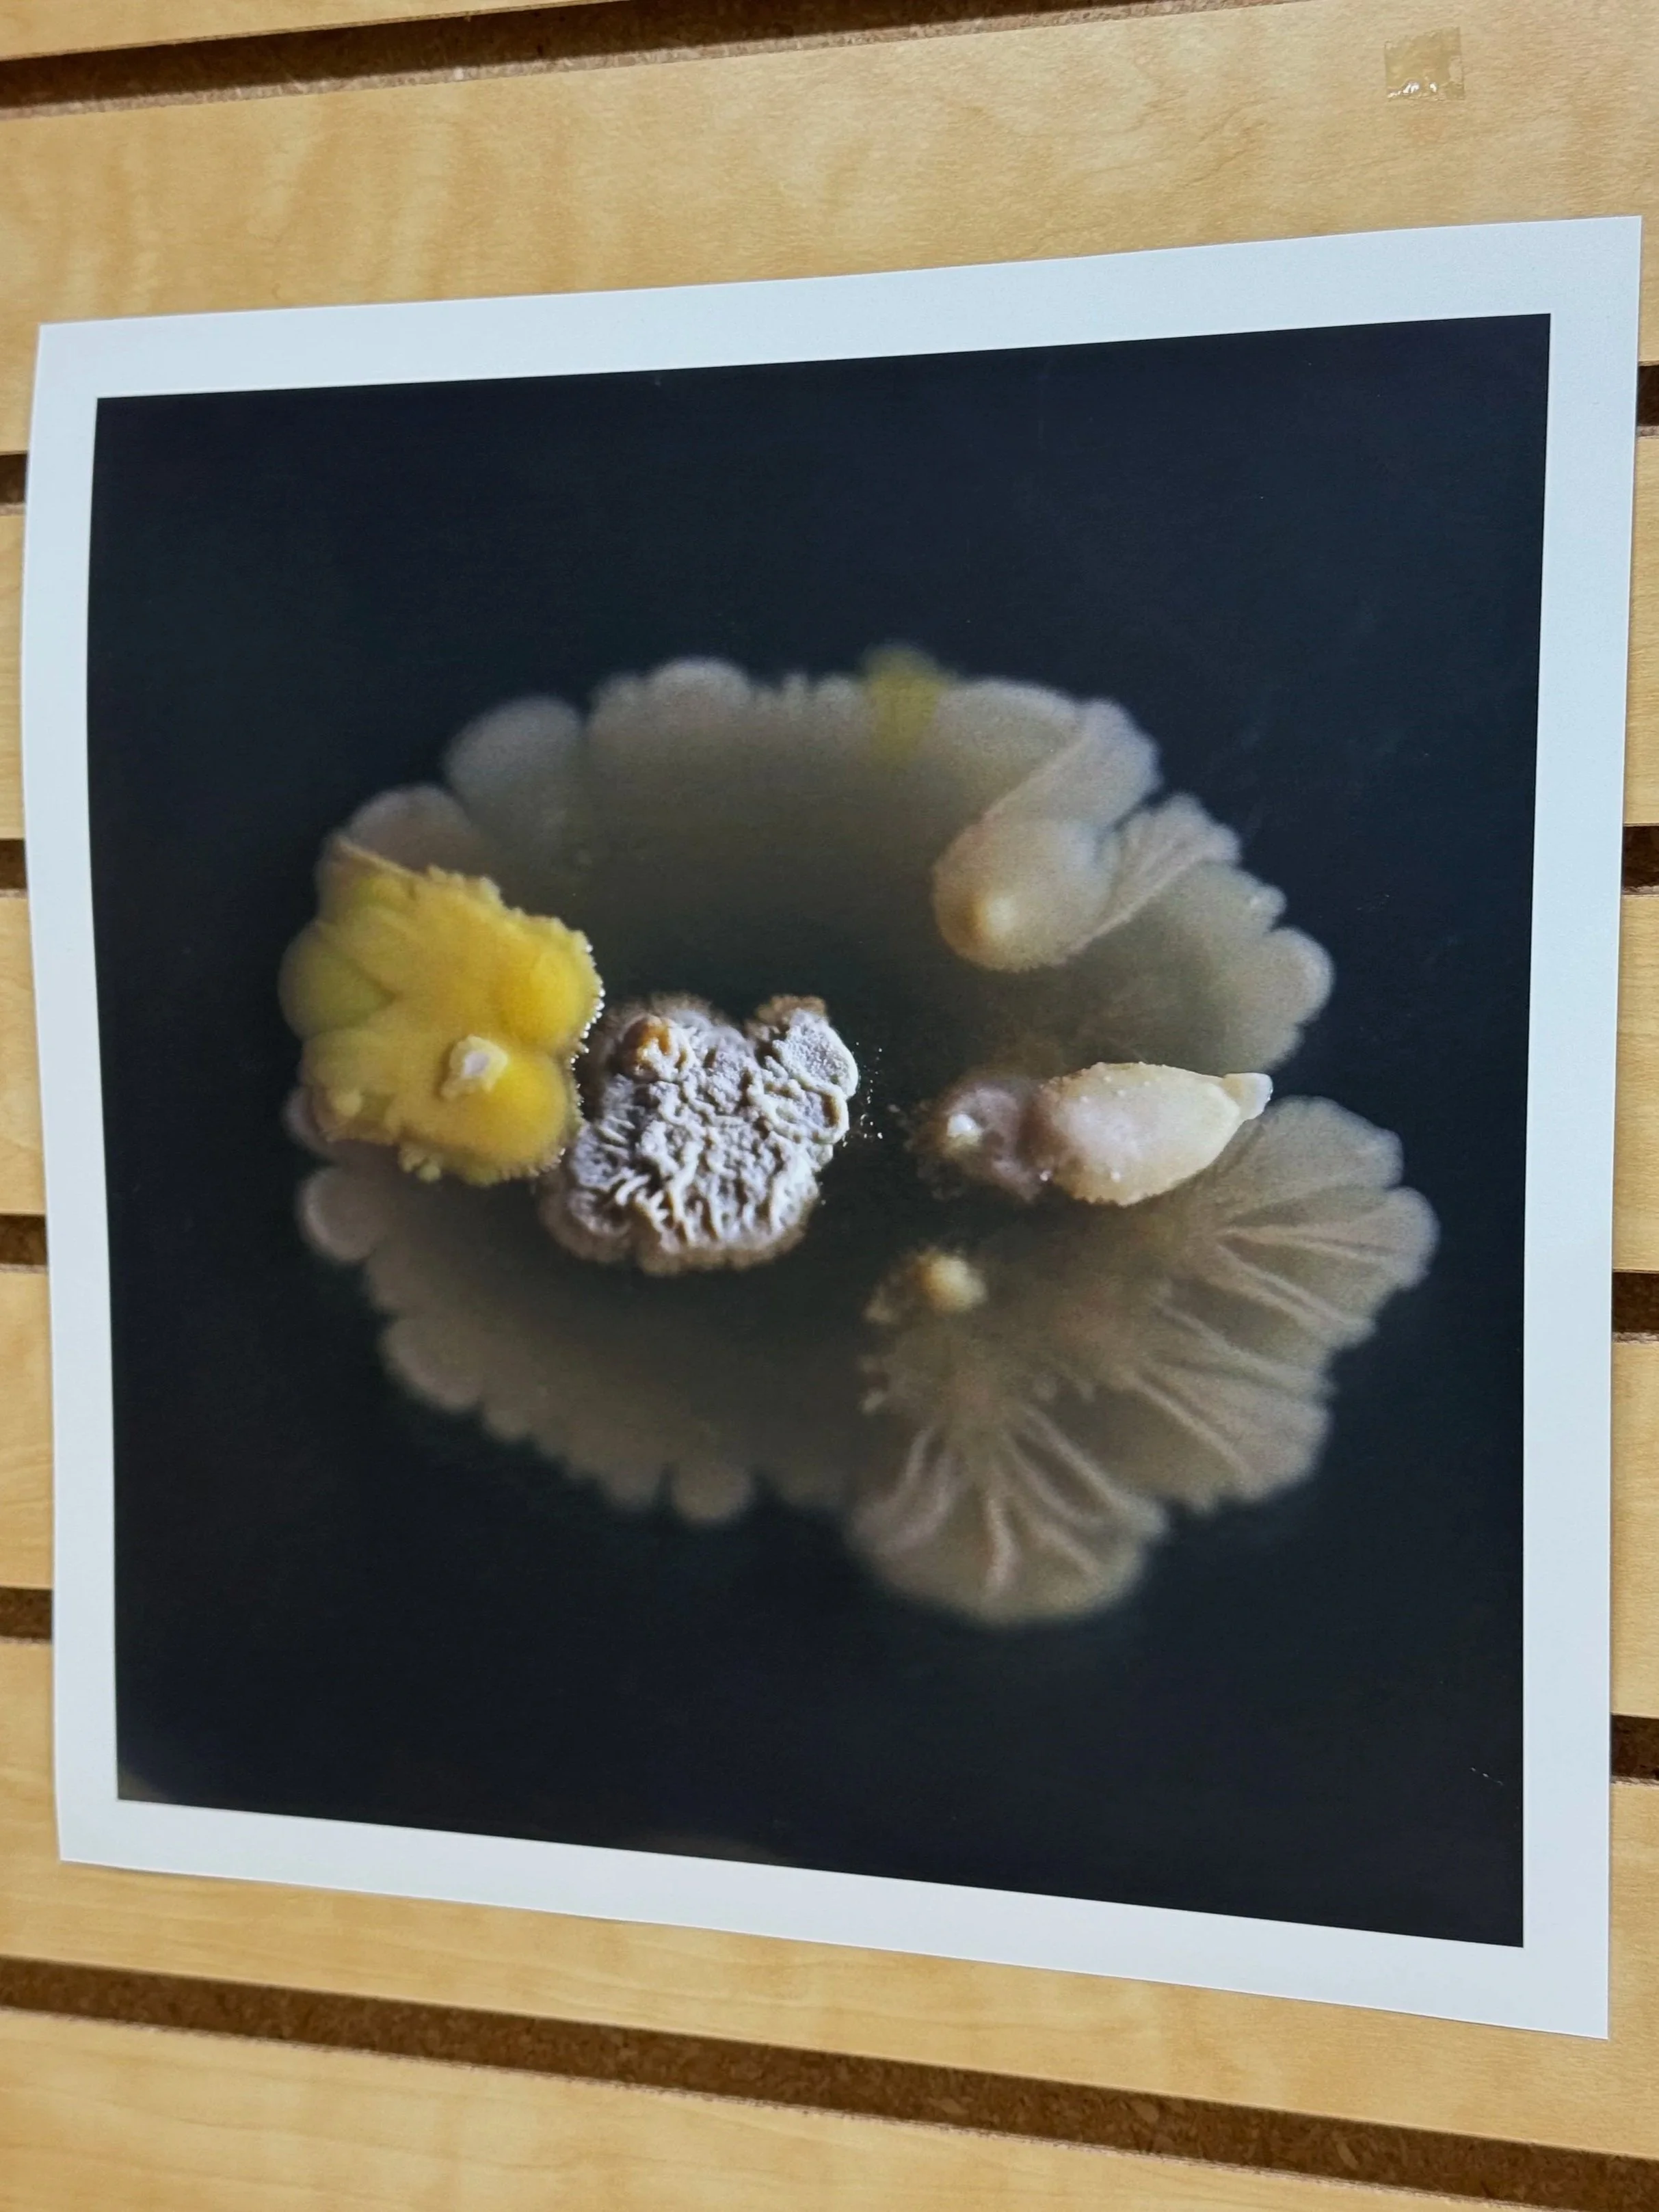
IMG_8930.jpg
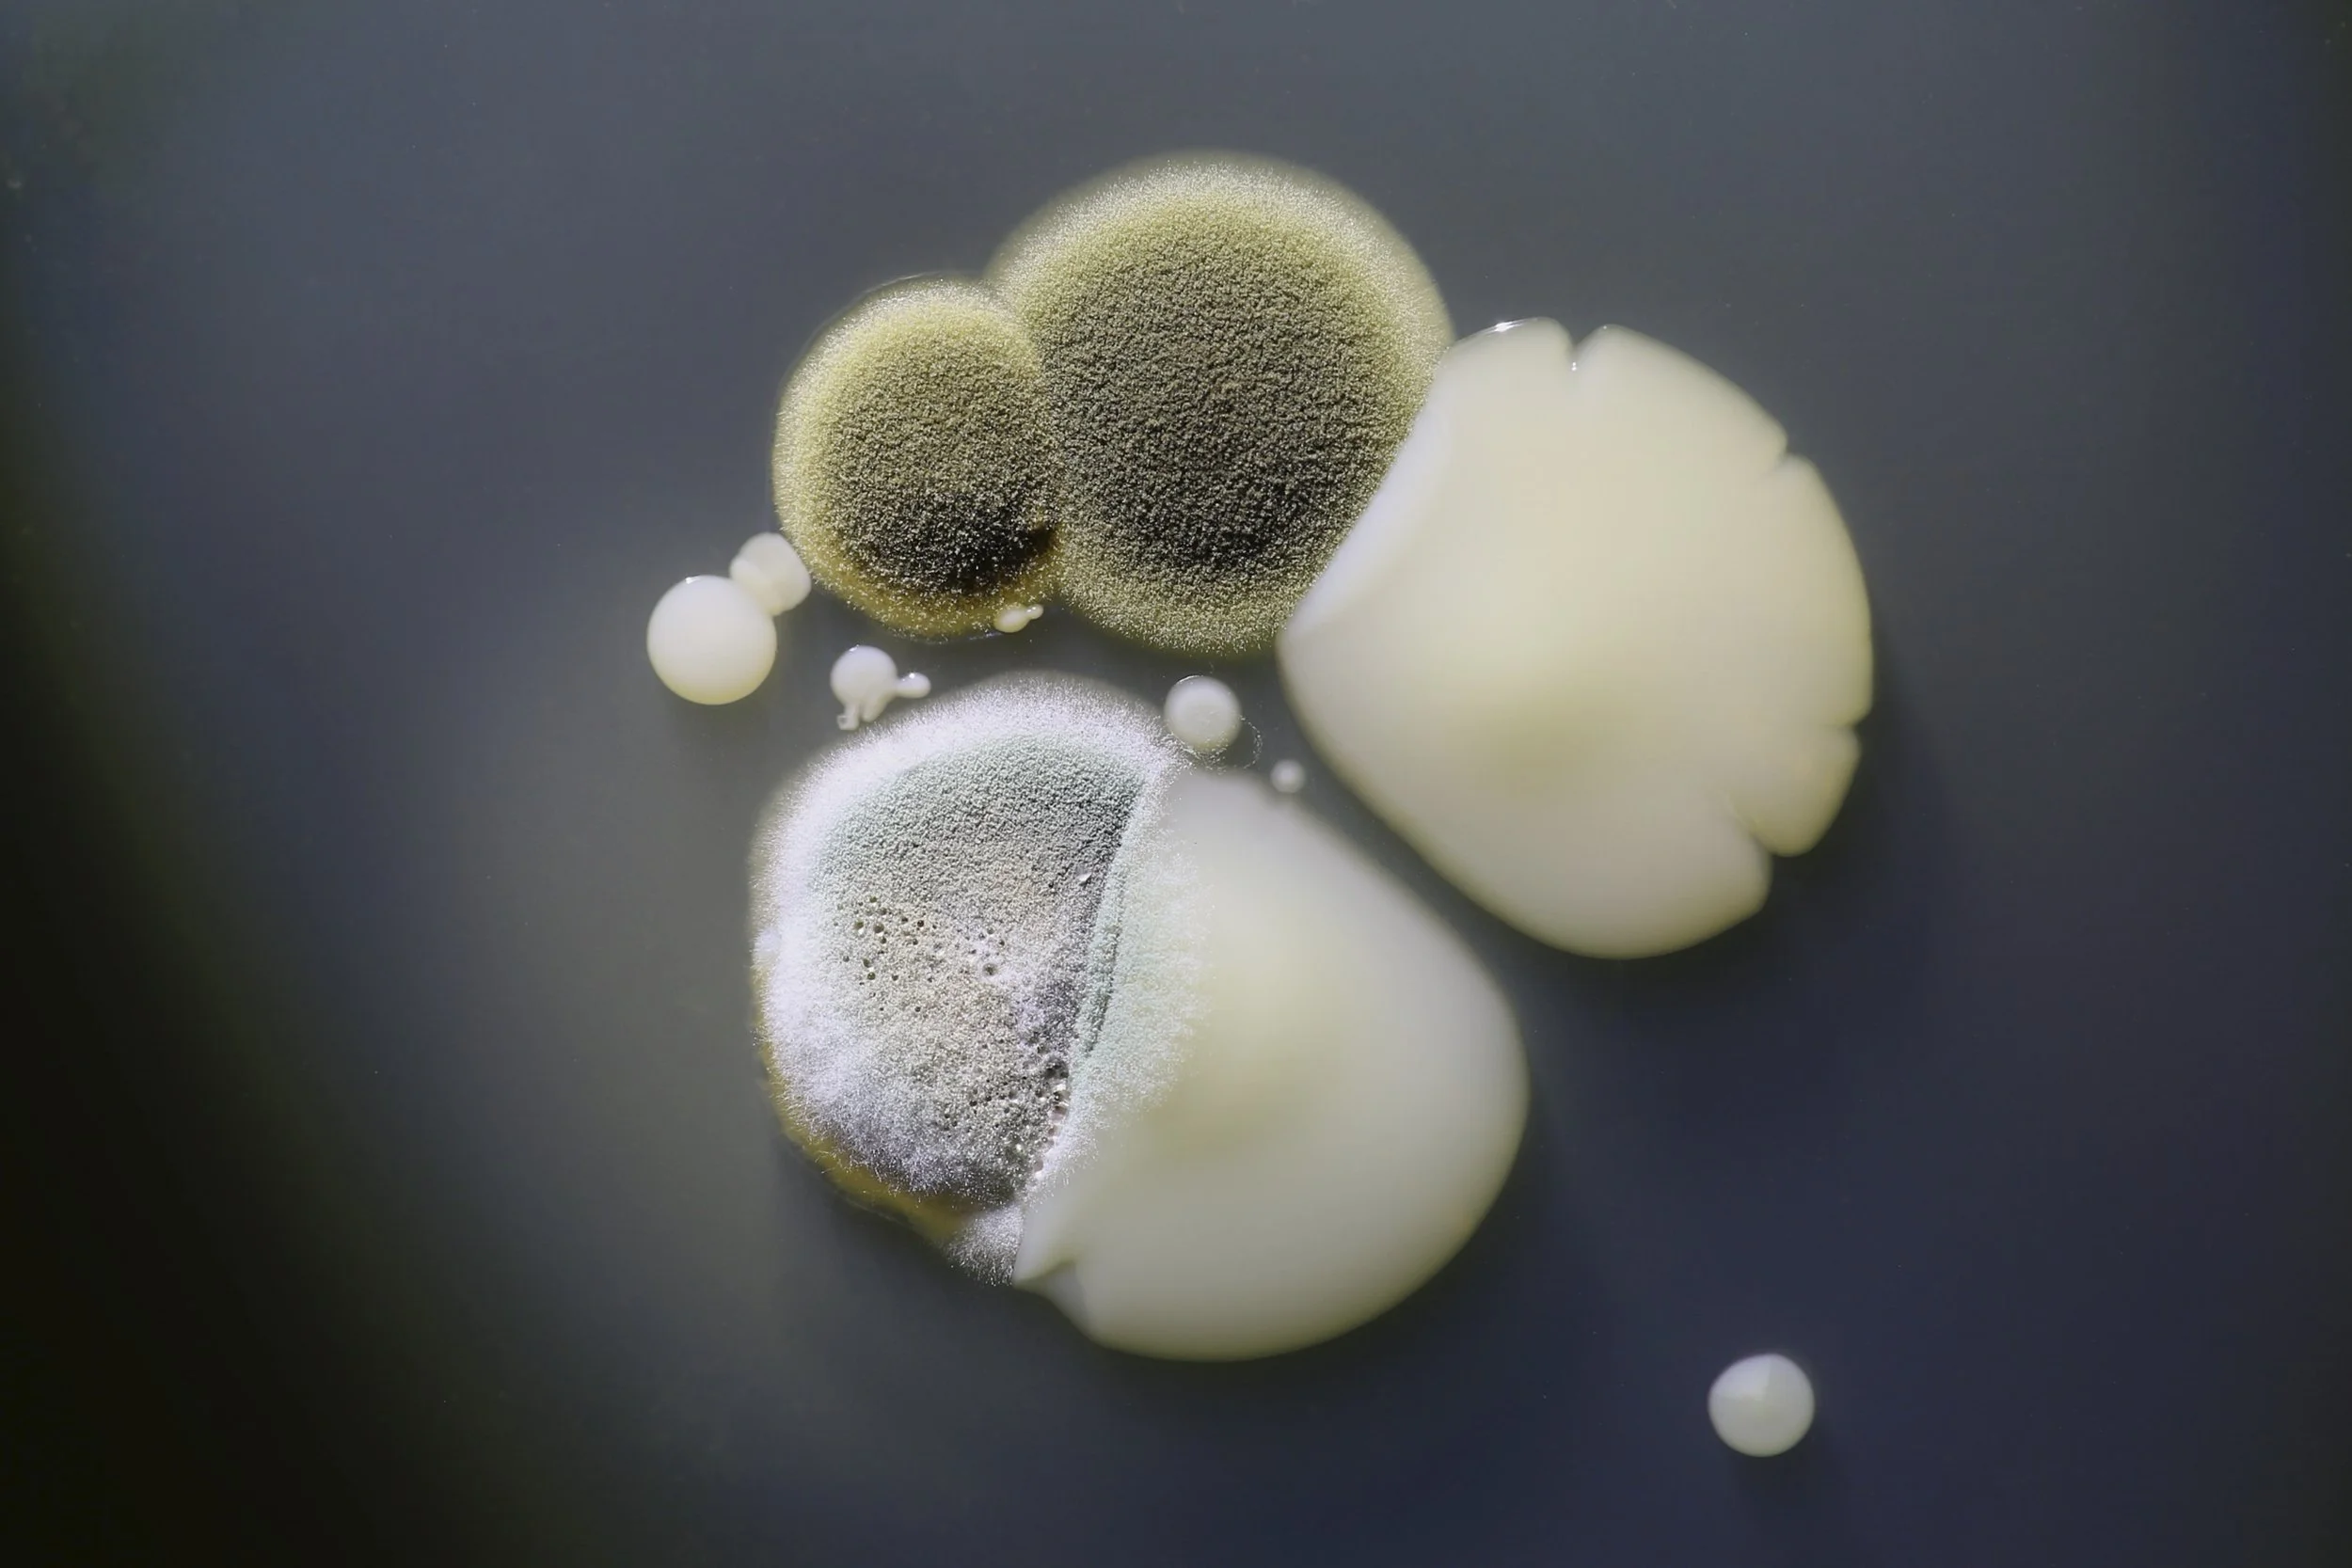
2.jpg

Curiouser and Curiouser
Unknown is a collaborative photographic study of microbial growth. After touching different everyday objects, we pressed our fingers onto petri dishes and allowed the organisms to grow into their own forms. Photographed with a Canon macro lens, the images enlarge these invisible traces of contact, turning small biological residues into unfamiliar landscapes. The lighting was supported by my collaborator Yunze Li.

Unknown, 2024
Photographs
Collaborative project
Canon macro lens
UDIST: Interdisciplinary Biodesign